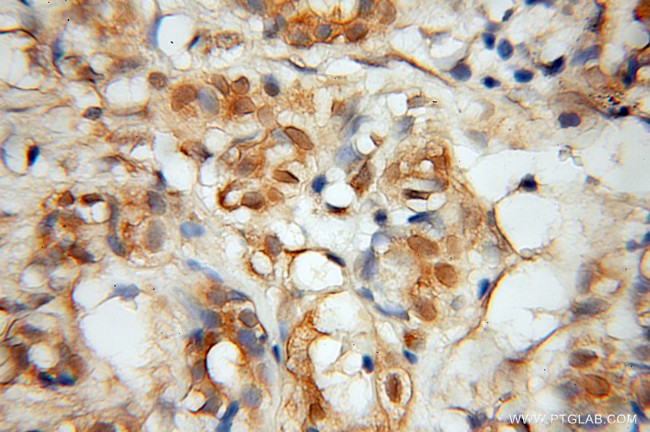
MINA Antibody in Immunohistochemistry (Paraffin) (IHC (P))

Search
Proteintech
MINA Polyclonal Antibody
{{$productOrderCtrl.translations['antibody.pdp.commerceCard.promotion.promotions']}}
{{$productOrderCtrl.translations['antibody.pdp.commerceCard.promotion.viewpromo']}}
{{$productOrderCtrl.translations['antibody.pdp.commerceCard.promotion.promocode']}}: {{promo.promoCode}} {{promo.promoTitle}} {{promo.promoDescription}}. {{$productOrderCtrl.translations['antibody.pdp.commerceCard.promotion.learnmore']}}
产品信息
12214-1-AP
种属反应
已发表种属
宿主/亚型
分类
类型
抗原
偶联物
形式
浓度
规格
纯化类型
保存液
内含物
保存条件
运输条件
产品详细信息
Immunogen sequence: SLVGSNVYI TPAGSQGLPP HYDDVEVFIL QLEGEKHWRL YHPTVPLARE YSVEAEERIG RPVHEFMLKP GDLLYFPRGT IHQADTPAGL AHSTHVTIST YQNNSWGDFL LDTISGLVFD TAKEDVELRT GIPRQLLLQV ESTTVATRRL SGFLRTLADR LEGTKELLSS DMKKDFIMHR LPPYSAGDGA ELSTPGGKLP RLDSVVRLQF KDHIVLTVLP DQDQSDETQE KMVYIYHSLK NSRETHMMGN EEETEFHGLR FPLSHLDALK QIWNSPAISV KDLKLTTDEE KESLVLSLWT ECLIQVV (160-465 aa encoded by BC014928 )
靶标信息
MINA is nuclear localized, myc-inducible protein that is thought to play a role in mammalian cell proliferation. Treatment of cancer cells lines such as the colon cancer cell line SW680 with siRNA against MINA inhibits cell growth, demonstrating that MINA may be a potential therapeutic target. MINA regulates several genes related to cell adhesion and metabolism that have also been shown to be regulated by c-Myc, but also regulates other genes whose expression are not modulated by c-Myc such as EGFR, IL-6 and HGF. MINA has also been found to act as a repressor to IL-4 expression in T cells, indicating that it may also play a role in T cell differentiation and genetic variation in T helper type 2 bias.
仅用于科研。不用于诊断过程。未经明确授权不得转售。
生物信息学
蛋白别名: 60S ribosomal protein L27a histidine hydroxylase; Bifunctional lysine-specific demethylase and histidyl-hydroxylase MINA; DKFZp762O1912; FLJ14393; Histone lysine demethylase MINA; MDIG2; cell cycle regulatory protein; mina; mina {ECO:0000312|RGD:708521}; Mina-53; mineral dust induced gene; mineral dust induced gene protein; mineral dust-induced gene; Mineral dust-induced gene protein; mineral dust-induced protein; mina53; nucleolar protein; NO52; ribosomal oxygenase 2; RIOX2; JMJD10; MYC induced nuclear antigen; MYC-induced nuclear antigen; MYC-induced nuclear antigen 53; myc-induced nuclear antigen, 53 kDa; Nucleolar protein 52; Protein mina53; Ribosomal oxygenase 2; Ribosomal oxygenase MINA; ROX; unnamed protein product
基因别名: 1810047J07Rik; 2410057H13Rik; 3830408E23Rik; AI449204; JMJD10; MDIG; MINA; MINA53; NO52; RIOX2; ROX
UniProt ID: (Mouse) Q8CD15, (Rat) Q8CFC1, (Human) Q8IUF8
Entrez Gene ID: (Mouse) 67014, (Rat) 266670, (Human) 84864